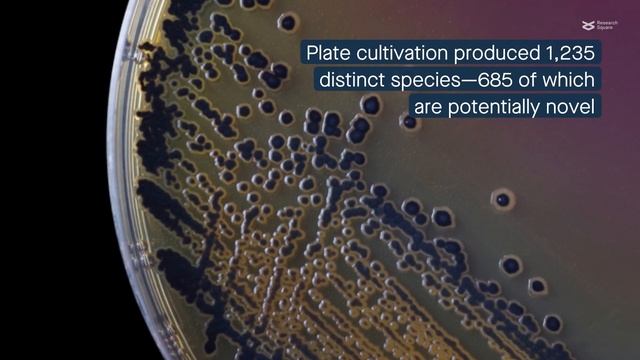
Exploring phycospheric bacteria in green, brown, and red algae смотреть онлайн

Автор / Канал: Blossom Bounty Страница 12

Святогорск. Пьянка с Гришей.

Днепрооблэнерго - Запад. 1 Лига
Exploring phycospheric bacteria in green, brown, and red algae

Видео с веб-камеры. Дата: 9 сентября 2012 г., 22:26.

Elmo raps

Food Pantry (Polish version)

школа 24
![TRYPKO - IF YOU LOVE ME [NO COPYRIGHT] | [БЕЗ АВТОРСКИХ ПРАВ] смотреть онлайн TRYPKO - IF YOU LOVE ME [NO COPYRIGHT] | [БЕЗ АВТОРСКИХ ПРАВ] смотреть онлайн](https://pic.rtbcdn.ru/video/2025-02-09/17/f7/17f7b88448a90e1669421cd1050e2373.jpg)
TRYPKO - IF YOU LOVE ME [NO COPYRIGHT] | [БЕЗ АВТОРСКИХ ПРАВ]

Clever Carriage Handcrafted Leather Rose Crossbody

Лилия Гадел. 100 лет ТАССР

NYC Vax Champ | Dr. Nicholas Morin Director Bariatric Surgery

Лама и плевки

Нецветные розы Диана Шурыгина песня

sufi je soz saz khe by jamal faqeer

SWR-Sommerfestival I 4 Tage Open-Air mit Herzenssache-Benefizkonzert

Снег и берёзки

Суть тренда показать свои страхи

#мирлюдей,#тароуроки,Какие силы правят людьми.Зло и Добро

Majisa Kathe Soya Re | Rajasthani SUPERHIT Song | Asha Vaishnav | 1080p HD VIDEO | Majisa Bhatiyani

Mагазин Dallar tree ,(семена и все остальное)Erie PA по 1,25

🌸Бумажные сюрпризы 🌸/РАССПОКОВКА+5 Приветиков 😇/Маша ^-^

С ДНЕМ РОЖДЕНИЯ

Нож «КЛЫЧЁК» 95Х18, кап клена артикул 11052

ENTRECOTE DRY AGED - BIZARRE WINTER MENU PREMIUM
За каждым успешным каналом стоит личность, идея и сотни часов кропотливого труда. Если вы здесь, значит, автор «Blossom Bounty» уже сумел зацепить ваше внимание своим уникальным стилем или подачей. А мы на RUVIDEO позаботились о том, чтобы вы могли изучить весь архив его работ в максимально комфортных условиях — без лишней суеты и преград.
Почему за работами канала «Blossom Bounty» так интересно наблюдать? Всё просто: это честный контент, который находит отклик в сердцах зрителей. На нашем ресурсе вы можете смотреть онлайн все видео любимого автора бесплатно и в хорошем качестве. Нам важно, чтобы вы видели каждую деталь и слышали каждый нюанс, поэтому мы используем только стабильные плееры из открытых источников Rutube.
Следите за новинками канала, пересматривайте старые шедевры и открывайте для себя новые грани творчества «Blossom Bounty». Мы постоянно обновляем ленту, чтобы у вас под рукой всегда были самые свежие выпуски. Никаких сложных регистраций — только вы и творчество, которое вдохновляет. Приятного вам путешествия по миру авторского контента на RUVIDEO!
Видео взято из открытых источников Rutube. Если вы правообладатель, обратитесь к первоисточнику.